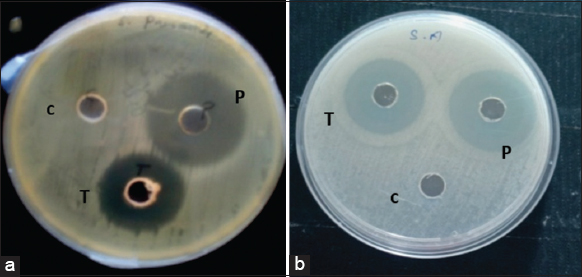

1. INTRODUCTION
Antibiotics saved millions of lives from the pathogenic infections. However, after the advent of multidrug resistance microorganisms, the conventional antibiotics become ineffective against pathogenic microbes [1]. Multidrug resistance, a global crisis, has necessitated the search of an effective antimicrobial agents to control the resistant bacteria. Drug-resistant microorganisms have emerged mainly due to the indiscriminate usage of broad-spectrum antibiotics against microbes [2,3]. This is a growing problem, particularly in hospitals where pathogenic bacteria get antibiotic resistance [4], which include methicillin-resistant Staphylococcus aureus and multi-drug resistant Mycobacterium tuberculosis [5].
Nature provides us many therapeutic products that are able to inhibit the growth of pathogenic microbes [6]. One of the natural products, the antibacterial peptides, has attracted much attention in recent days as a new therapeutic agent against the drug resistant microbial pathogens. These antimicrobial peptides (AMPs) have been reported to found in broad spectrum of organisms which include microbes, plants, and whole of the animal kingdom including invertebrates and vertebrates [7]. It is interesting that the diversity, complexity, and variety of the AMPs seem to be much wider than expected [8].
Among the animal kingdom, Phylum Arthropoda is the largest phylum with diverse group of organisms and account for more than 80% of all known living animal species [9]. The first AMP from arthropods was isolated from the moth Hyalophora cecropia, known as Cecropins [10]. After that, many AMP from other arthropods came to limelight in pharmaceutical industry and several AMPs have been reported in several scorpions and spiders [11]. Gomesin is the first AMP identified from the hemolymph of spiders [12]. Interestingly, spider AMPs showed sequence similarities to Protegrins, an AMP from porcine leukocytes [8].
Due to their potent antibacterial activity against antibiotic-resistant bacteria, AMPs have emerged as a novel class of antibiotics and a promising therapeutic option for many infections caused by multidrug-resistant bacteria [13]. The persistence of different invertebrate populations in a contaminated environmental niche supports the development of disease-fighting AMPs [14-16]. For example, invertebrates such as cockroaches and centipedes thrive in polluted settings and frequently exposed to dangerous bacteria and disease-causing substances, showing the presence of natural AMPs in their bodies to nullify the pathogens [17-19]. There are limited publications on the spider hemolymph’s antibacterial properties [8,20,21]. Spiders are regarded as one of the most abundant and technologically advanced suppliers of these peptide compounds due to their diversity [17,22].
Several studies have been attempted to test the spider’s hemolymph’s potential as antimicrobial agent, which includes the hemolymph of the spiders such as Lycosa singoriensis [23], Agelena labyrinthica [8], Loxosceles intermedia [24], and Acanthoscurria rondoniae [25]. However, the full potential of AMPs in spiders is yet to be explored. In this context, we studied the antimicrobial potential of hemolymph of Indian cooperative spider Stegodyphus sarasinorum and Golden orb web spider Nephila pilipes against microbial pathogens. Further, we quantify the proteins present in the spider’s hemolymph and made an effort to separate the proteins from the spider hemolymph.
2. MATERIALS AND METHODS
2.1. Study Species
The Indian cooperative spider S. sarasinorum belongs to the family Eresidae. It is widely distributed in India, Nepal, Sri Lanka, and Myanmar. The female of S. sarasinorum is nearly 1 cm and the male is nearly 0.5 cm (excluding the legs). This spider exhibits communal predation and feeding [26], where individuals live in large cooperatively built nests [27].
N. pilipes is commonly called as Giant Wood Spider. The female is 35–45 mm and the male is about 2–4 mm. It is distributed widely in East and Southeast Asia as well as Oceania [28]. These spiders construct gigantic orb webs, often reaching a length of 1.5–2 m in diameter. The males usually die soon after mating [29].
2.2. Hemolymph Collection
Permission was obtained from Periyar University Departmental Animal Ethical Committee before the collection of spiders hemolymph. These spiders were collected from the nearby scrub land and reared in cages under laboratory conditions. They were fed with insects such as grasshoppers, katydids, moths, and mosquitoes for 10 days before the hemolymph extraction. These spiders were narcotized with 70% ethanol, then, their fourth walking leg was separated from the coxa. The flowing whitish-brown hemolymph was collected with micropipettes as per Yigit and Benl, [8]. Nearly, 10 μL of hemolymph was obtained from each spider. The hemolymph is diluted in the range of 1/1 with insect saline solution (insect saline solution: 1.80 g NaCl, 1.88 g KCl, 0.16 g CaCl2, 0.004 g NaHCO3, and 100 μL distilled water).
2.3. Determination of Antimicrobial Potential
The antimicrobial activity of resultant hemolymph – saline solution mixture was tested against ten different pathogenic bacterial strains such as S. aureus, Pseudomonas aeruginosa, Staphylococcus epidermidis, Streptococcus agalactiae, Staphylococcus hominis, Streptococcus pneumoniae, Klebsiella pneumonia, Staphylococcus saprophyticus, Salmonella spp., and Shigella spp. The strains were inoculated in Mueller–Hinton broth (MHB) (Merck) and incubated at 37°C for 24 h.
The antimicrobial potential was evaluated by the agar well diffusion method [30]. The bacterial culture medium was prepared by suspending 38 g of Muller–Hinton agar medium in 1 L of water. After sterilization, the media was poured into sterile glass Petri dishes followed by inoculation of 100 mL of the culture broth. The hemolymph-saline solution mixture was poured in one well of each agar plate containing microorganisms and incubated at 37°C for 24 h. The rest of the wells were loaded with gentamicin and saline solution for positive and negative control, respectively. The antagonistic activity of hemolymph was measured in mm called as zone of inhibition (ZI).
2.4. Minimum Inhibitory Concentration (MIC)
MIC was determined by broth dilution method [31]. About 0–120 μL/mL of hemolymph – saline solution was incubated in the pathogen inoculated broth for 24 h at 37°C. The conventional 96-well plates with MHB with different concentrations of hemolymph, against pathogens were incubated to find out the MIC. The MIC values were calculated to identify the lowest concentration of the extract that inhibits the growth of the pathogens [32,33]. After incubation, absorbance was measured at 595 nm using a microplate reader (Bio-Rad).
2.5. Electrophoretic Analysis of the Hemolymph Proteins
The protein profile of the hemolymph bands was analyzed by electrophoresis with continuous gradient 15% (w/v) polyacrylamide gels under reducing and non-reducing conditions following Laemmli [34]. They were visualized with the aid of Coomassie blue R-250 staining protocol [35] in Sodium dodecyl-sulfate (SDS) polyacrylamide gel electrophoresis (PAGE) [34,36,37]. The electrophoresis was carried out at a constant voltage of 100 V for 3 h. In these analyses, a hemolymph pool from 20 spiders of S. sarasinorum and N. pilipes were used. The molecular mass markers were acquired from Sigma (Sigma Aldrich, USA).
2.6. Quantification of Total Hemolymph Proteins
A total of 60 μL clear supernatant mixture of hemolymph-saline solution (1:1 ratio) was inoculated by dye-binding method of Bradford (1976) with bovine serum albumin (BSA) as control. The total protein content of hemolymph was represented in mg/mL. The quantification was done using a spectrophotometer at 595 nm (UNICO Spectrophotometer, SP2100 UV, China) [38].
3. RESULTS
The hemolymph of S. sarasinorum demonstrated remarkable antibacterial activity against eight out of ten pathogenic test organisms. The maximum and minimum ZI obtained were against S. pneumoniae (15 mm) and S. agalactiae (1.5 mm), respectively, while the hemolymph of N. pilipes exhibited antimicrobial activity against five out of ten test organisms, with the maximum and minimum ZI in S. aureus (10.5 mm) and S. epidermidis (5 mm), respectively [Figure 1]. There is a significant difference observed between the ZI formed by S. sarasinorum and N. pilipes [Figure 2] (F2, 27 = 19.41, P = 0.0001).
| Figure 1: The maximum Zone of Inhibition formed due to the antibacterial activities of the colonial spider (a). Stegodyphus sarasinorum against Streptococcus pneumoniae and Golden orb web spider (b). Nephila pilipes hemolymph extract against Staphylococcus aureus. [Click here to view] |
 | Figure 2: Effect of antimicrobial activities of spiders hemolymph against pathogenic bacteria. [Click here to view] |
The antibacterial activities of the hemolymph extract were identified against the test pathogens as S. aureus. Among the test bacteria, the MIC was 325 μg/mL for S. aureus. The protein content was determined using a standard curve prepared based on BSA with a Bradford Coomassie blue method the linear equation between protein content and absorption value was y = 0.021× + 0.118, R2 = 0.932 for S. sarasinorum, and y = 0.032× + 0.077, R² = 0.974 for N. pilipes [Figure 3]. The protein quantified in N. pilipes and S. sarasinorum was 91.8 μg/mL and 16.10 μg/mL, respectively.
 | Figure 3: Quantification of total hemolymph proteins in bovine serum albumin (a). Stegodyphus sarasinorum and (b). Nephila pilipes. [Click here to view] |
The protein profile of S. sarasinorum and N. pilipes hemolymph reveals that they are rich in several electrophoretic mobility-associated protein bands, ranging between 15 kDa and 200 kDa. The dominant bands in the protein profile of S. sarasinorum and N. pilipes were in the range of 60–100 kDa and 50–120 kDa respectively [Figure 4].
 | Figure 4: The analysis of proteins in the hemolymph of different spider species using 15% SDS-PAGE – (a) Stegodyphus sarasinorum and (b) Nephila pilipes. [Click here to view] |
4. DISCUSSION
In this study, antimicrobial activities of S. sarasinorum and N. pilipes’s hemolymph were tested against ten pathogenic microbes. Our analysis showed that S. sarasinorum showed antimicrobial activity against eight pathogenic bacteria, whereas N. pilipes showed antimicrobial activity against five pathogenic bacteria. This showed that S. sarasinorum AMPs have wide spectrum antimicrobial activity compared to the hemolymph AMPs of N. pilipes. Hemolymph of S. sarasinorum showed the maximum (ZI) against the pathogenic bacterium S. pneumoniae, while the hemolymph of N. pilipes exhibited maximum ZI against the pathogenic bacterium S. aureus (10.5 mm). Similarly, Yigit and Benli [8] reported that the hemolymph of the spider A. labyrinthica showed antimicrobial activity against five out of ten pathogenic bacteria. This showed that our two species of spiders hemolymph showed promising antimicrobial activities. Further, this also revealed that antimicrobial activity of spiders hemolymph vary between the species. The hemolymph of Lasiodora sp. exhibited antagonistic behavior against Enterococcus faecalis and Bacillus subtilis with MIC of 3400 μg/mL [39]. While, in our study, the growth of S. aureus was inhibited at MIC of 325 μg/mL of S. sarasinorum hemolymph. The MIC of Gomesin purified from Acanthocurria gomesiana’s hemolymph against a wide range of bacteria, fungi and eukaryotic cells represent their effective antagonistic nature [25]. Not only the antibacterial peptides, even an effective antifungal peptide, have been isolated from the hemolymph of A. rondoniae [25]. However, we analyze only the antibacterial properties of the spider hemolymph.
In the present study, the protein profile of S. sarasinorum and N. pilipes hemolymph reveals that they are rich in several electrophoretic mobility-associated protein bands, ranges between 15 kDa and 200 kDa. Our findings corroborate with the analysis of hemolymph of other spider species such as Nephila inaurata [40], Cupiennus salei, Eurypelmacali fornicum, and Eurypelma helluo [41]. Similarly, Jalal [42] analyzed hemolymph of ten species of spiders in citrus orchard and found 200 kDa and 60 kDa bands in all species of spiders.
This study demonstrated that the hemolymph of S. sarasinorum and N. pilipes was effective against most of the tested pathogenic bacteria. Consequently, to develop effective new drugs against antibiotic-resistant microorganisms, the hemolymph of spiders may be used as a potentially new source of natural antibacterial agents. The protein profile of the hemolymph has been studied. However, the active AMPs from the hemolymph need to be isolated and purified for further studies.
5. CONCLUSION
We reported the antimicrobial activities of hemolymph of two species of spiders S. sarasinorum and N. pilipes. In this study, S. sarasinorum showed antimicrobial activity against eight pathogenic bacteria and N. pilipes against five. This study clearly portrays the wide spectrum antimicrobial activity of S. sarasinorum hemolymph. Further, we estimated the molecular weight of the hemolymph proteins and isolated them with SDS PAGE. The protein profile of hemolymph revealed that their dominant band in the range of 60–100 kDa in S. sarasinorum and 50–120 kDa in N. pilipes. Further studies regarding separation of active AMPs from the hemolymph need to be done for the future studies. Studies of AMPs produce novel perspectives on pathogenicity and provide new perspectives on the interrelations between pathogens and their hosts. This study will serve as the foundation for our future research on enhanced purification, protein type characterization, and the action mechanisms of their active ingredients into the molecular pathways will be highly beneficial in the development of novel medications that utilize spider hemolymph.
6. ACKNOWLEDGMENT
We thank the Masters student who helped us in spider collection. We also thank Periyar University, India and National Pingtung University of Science and Technology for providing us with necessary facilities to carry out the research.
7. AUTHORS’ CONTRIBUTIONS
PTN contributed to the conception of the research idea. While the acquisition, analysis, or interpretation of data was carried out by DS and PSA. The laboratory facilities and chemicals were provided by DJHS. The initial draft was written by DS and PSA. The final draft was prepared by DS, PSA, and PTN.
8. FUNDING
This study was funded by TEEP@AsiaPlus Program funded by Ministry of Education, Taiwan and Periyar University Research Fellowship (URF) to DS (PU/ADs3/URF/2018).
9. CONFLICTS OF INTEREST
The authors declare no conflicts of interest in this work.
10. ETHICAL APPROVALS
This study does not involve experiments on animals or human subjects.
11. DATA AVAILABILITY
Data are available with the corresponding author of this publication upon reasonable request.
12. PUBLISHER’S NOTE
This journal remains neutral with regard to jurisdictional claims in published institutional affiliation.
REFERENCES
1. Aslam B, Wang W, Arshad MI, Khurshid M, Muzammil S, Rasool MH, et al. Antibiotic resistance:A rundown of a global crisis. Infect Drug Resist 2018;11:1645-58. [CrossRef]
2. Fair RJ, Tor Y. Antibiotics and bacterial resistance in the 21st century. Perspect Medicin Chem 2014;6:25-64. [CrossRef]
3. Tang KL, Caffrey NP, Nóbrega DB, Cork SC, Ronksley PE, Barkema HW, et al. Restricting the use of antibiotics in food-producing animals and its associations with antibiotic resistance in food-producing animals and human beings:A systematic review and meta-analysis. Lancet Planet Health 2017;1:e316-27. [CrossRef]
4. Ali SM, Siddiqui R, Sagathevan KA, Khan NA. Antibacterial activity of selected invertebrate species. Folia Microbiol (Praha) 2021;66:285-91. [CrossRef]
5. Klein E, Smith DL, Laxminarayan R. Hospitalizations and deaths caused by methicillin-resistant Staphylococcus aureus, United States, 1999-2005. Emerg Infect Dis 2007;13:1840-6. [CrossRef]
6. Haeberli S, Kuhn-Nentwig L, Schaller J, Nentwig W. Characterisation of antibacterial activity of peptides isolated from the venom of the spider Cupiennius salei (Araneae: Ctenidae). Toxicon 2000;38:373-80. [CrossRef]
7. Huan Y, Kong Q, Mou H, Yi H. Antimicrobial peptides:Classification, design, application and research progress in multiple fields. Front Microbiol 2020;11:582779. [CrossRef]
8. Yigit N, Benli M. The antibacterial activity of hemolymph of spider, Agelena labyrinthica (Araneae:Agelenidae). Kastamonu Univ J For Fac 2008;8;120-4.
9. Ødegaard F. How many species of arthropods?Erwin's estimate revised. Biol J Linn Soc 2000;71:583-97. [CrossRef]
10. Steiner H, Hultmark D, Engström Å, Bennich, H, Boman HG. Sequence and specificity of two antibacterial proteins involved in insect immunity. Nature 1981;292;246-8. [CrossRef]
11. Kuhn-Nentwig L. Antimicrobial and cytolytic peptides of venomous arthropods. Cell Mole Life Sci 2003;60;2651-68. [CrossRef]
12. Mandard N, Bulet P, Caille A, Daffre S, Vovelle F. The solution structure of gomesin, an antimicrobial cysteine?rich peptide from the spider. Eur J Biochem 2002;269 1190-8. [CrossRef]
13. Giuliani A, Pirri G, Nicoletto SF. Antimicrobial peptides:An overview of a promising class of therapeutics. Cent Eur J Biol 2007;2;1-33. [CrossRef]
14. Fratini F, Cilia G, Turchi B, Felicioli A. Insects, arachnids and centipedes venom:A powerful weapon against bacteria. A literature review. Toxicon 2017;130:91-103. [CrossRef]
15. Jozefiak A, Engberg RM. Insect proteins as a potential source of antimicrobial peptides in livestock production. A review. J Anim Feed Sci 2017;26:87-99. [CrossRef]
16. Wu Q, Patocka J, Kuca K. Insect antimicrobial peptides, a mini review. Toxins (Basel) 2018;10:461. [CrossRef]
17. Ali SM, Siddiqui R, Ong SK, Shah MR, Anwar A, Heard PJ, et al. Identifcation and characterization of antibacterial compound(s) of cockroaches (Periplaneta americana). Appl Microbiol Biotechnol 2017;101:253-86. [CrossRef]
18. Jeyamohan P, Hasumura T, Nagaoka Y, Yoshida Y, Maekawa T, Kumar DS. Accelerated killing of cancer cells using a multifunctional single-walled carbon nanotube-based system for targeted drug delivery in combination with photothermal therapy. Int J Nanomedicine 2013;8:2653-67. [CrossRef]
19. Akbar N, Siddiqui R, Iqbal M, Sagathevan K, Khan NA. Gut bacteria of cockroaches are a potential source of antibacterial compound(s). Lett Appl Microbiol 2018;66:416-26. [CrossRef]
20. Pereira LS, Silva PI Jr., Miranda MT, Almeida IC, Naoki H, Konno K, et al. Structural and biological characterization of one antibacterial acylpolyamine isolated from the hemocytes of the spider Acanthocurria gomesiana. Biochem Biophys Res Commun 2007;352:953-9. [CrossRef]
21. Freitas CI, Paiva ES, Dias EV, Carmo FN, Serafim MK, Oliveira AF, et al. Antimicrobial activity of semi-árido spider haemolymph Acanthoscurria parahybana (Araneae:Theraphosidae). In IX symposium of the Brazilian society on toxicology. J Venomous Anim Toxins Including Trop Dis 2007;13;216.
22. Sheikh IA, Yasir M, Khan I, Khan SB, Azum N, Jiffri EH, et al. Lactoperoxidase immobilization on silver nanoparticles enhances its antimicrobial activity. J Dairy Res 2018;85:460-4. [CrossRef]
23. Xu K, Ji Y, Qu X. Purification and characterization of an antibacterial peptide from venom of Lycosa singoriensis. Acta Zool Sin 1989;35:300-5.
24. Bednaski AV, Trevisan-Silva D, Matsubara FH, Boia-Ferreira M, Olivério MM, Gremski LH, et al. Characterization of brown spider (Loxosceles intermedia) hemolymph:Cellular and biochemical analyses. Toxicon 2015;98:62-74. [CrossRef]
25. Riciluca KC, Sayegh RS, Melo RL, Silva PI Jr. Rondonin an antifungal peptide from spider (Acanthoscurria rondoniae) haemolymph. Results Immunol 2012;2:66-71. [CrossRef]
26. Willey MB, Jackson RR. Predatory behavior of a social spider, Stegodyphus sarasinorum (Araneae:Eresidae):Why attack first?Can J Zool 1993;71:2220-3. [CrossRef]
27. Chakraborty A. A Numerical Study of Modelling in a Predator-Prey System. Doctoral Dissertation. Australia:Swinburne University of Technology, Faculty of Engineering and Industrial Sciences;2009.
28. World Spider Catalog. Version 23.0. Natural History Museum Bern. Available from:https://www.wsc.nmbe.ch [Last accessed on 2022 Feb 18].
29. Sebastian PA, Peter KV. Spiders of India. India:Universities Press;2009.
30. Missoun F, de los Ríos AP, Ortiz-Martínez V, Salar-García MJ, Hernández-Fernández J. Discovering low toxicity ionic liquids for Saccharomyces cerevisiae by using the agar well diffusion test. Processes 2020;8:1163. [CrossRef]
31. Ehret-Sabatier L, Loew D, Goyffon M, Fehlbaum P, Hoffmann JA, van Dorsselaer A, et al. Characterization of novel cysteine-rich antimicrobial peptides from scorpion blood. J Biol Chem 1996;271:29537-44. [CrossRef]
32. Vora J, Srivastava A, Modi H. Antibacterial and antioxidant strategies for acne treatment through plant extracts. Inform Med Unlocked 2018;13:128-32. [CrossRef]
33. Laemmli UK. Cleavage of structural proteins during the assembly of the head of bacteriophage T4. Nature 1970;227;680-5. [CrossRef]
34. Wray W, Boulikas T, Wray VP, Hancock R. Silver staining of proteins in polyacrylamide gels. Anal Biochem 1981;118:197-203. [CrossRef]
35. Tambourgi DV, Da Silva MD, Billington SJ, De Andrade RM, Magnoli FC, Songer JG, et al. Mechanism of induction of complement susceptibility of erythrocytes by spider and bacterial sphingomyelinases. Immunology 2002;107:93-101. [CrossRef]
36. Yi?it N, Güven T, Bayram A, Çavu?o?lu K. A morphological study on the venom apparatus of the spider Agelena labyrinthica (Araneae, Agelenidae). Turk J Zool 2004;28:149-53.
37. Bradford MM. A rapid and sensitive method for the quantitation of microgram quantities of protein utilizing the principle of protein-dye binding. Anal Biochem 1976;72:248-54. [CrossRef]
38. Soares T, Ferreira FR, Gomes FS, Coelho LC, Torquato RJ, Napoleão TH, et al. The first serine protease inhibitor from Lasiodora sp. (Araneae:Theraphosidae) hemocytes. Process Biochem 2011;46:2317-21. [CrossRef]
39. Silva PI Jr., Daffre S, Bulet P. Isolation and characterization of gomesin, an 18-residue cysteine-rich defense peptide from the spider Acanthoscurria gomesiana hemocytes with sequence similarities to horseshoe crab antimicrobial peptides of the tachyplesin family. J Biol Chem 2000;275:33464-70. [CrossRef]
40. Averdam A, Markl J, Burmester T. Subunit sequences of the 4×6-mer hemocyanin from the golden orb-web spider, Nephila inaurata. Eur J Biochem 2003;270:3432-9. [CrossRef]
41. Markl J, Stöcker W, Runzler R, Kempter B, Bijlholt MM, Van Bruggen EF. Subunit heterogeneity, quaternary structure and immunological relationship of arthropod hemocyanins. Life Chem Rep Suppl 1983;1:39-42.
42. Jalal F, Mushtaq S, Parvez S, Rana SA, Suhail A. Partial characterization of hemolymph of different spider species of citrus orchards. Int J Agric Biol 2010;1;12:e450.